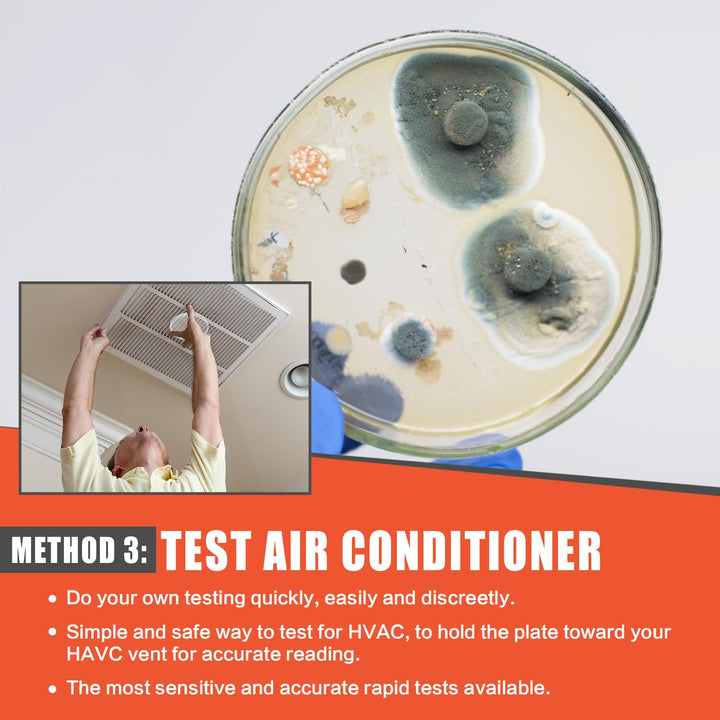
Mold Test Kit for Home Air Quality - 5 Individual DIY Home Mold Air Test Kit - Mold Detector for Home Air & Surface, HVAC Indoor Quick Mold Testing Kit for Home, Identification Guide Included
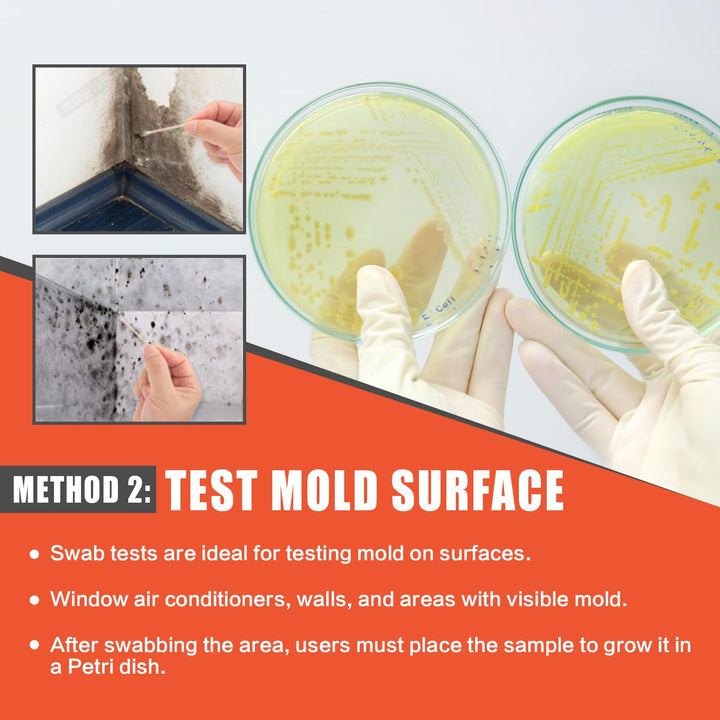
Mold Test Kit for Home Air Quality - 5 Individual DIY Home Mold Air Test Kit - Mold Detector for Home Air & Surface, HVAC Indoor Quick Mold Testing Kit for Home, Identification Guide Included

Brand: Revanak
Features:
- COMPLETE MOLD TESTING KIT: The Revanak mold air test kit for home air quality, surface and HVAC system, including 5 agar petri dishes, 10 cotton-tipped swabs, a detailed identification guide, This versatile air quality testing kit allows for a detailed air quality check throughout your home, pinpointing various mold types.for easy sample collection and provides accurate and reliable results for peace of mind!
- VERSATILE INDOOR TESTING: With the flexibility to assess both indoor environments.DIY Black Mold Test Kit for home is equipped for extensive environmental scrutiny, adept at performing indoor air testing . It effectively detects unseen mold in living spaces areas, from attic,basement, car, bedroom, car, kitchen, office and HVAC system,any Indoor place surface testing needs!
- THREE TESTING METHODS FOR COMPERHENSIVE ANALYSIS: REVANAK's home mold testing kit provides a multifaceted approach to mold detection in your home. Opt for an Indoor Air Quality Test to survey the overall atmosphere, utilize the Air Conditioning & Heating Sample Method for a detailed check of your climate control systems, or select the Surface Sampling Testing Method to directly address and analyze visible mold. This adaptable air mold detector kit ensures thorough mold assessment in any area of concern.
- 48-HOUR VISIBLE MOLD DETECTION: Seamlessly identify mold presence with REVANAK's Black Mold Detector for Home. This efficient and reliable mold testing kit for air quality offers a straightforward home testing for mold process, ensuring you can detect mold confidently. Obtain clear, visible results in as little as 48 hours for prompt and assured action.
- PEACE OF MIND ASSURANCE: Our mold air tester kit for home is designed to give you the confidence and peace of mind you deserve. It tests for the presence of thousands of mold, keeping your family safe and ensuring the well-being of your loved ones. Trust in your home air mold test kit to provide the assurance you need for a healthy and worry-free environment.
Part Number: RT-1854
EAN: 0762730343924
Package Dimensions: 7.2 x 5.1 x 4.2 inches
COSTS
TOTAL DELIVERY TIME (INCLUDING PROCESSING TIME)
Standard Shipping (USA and Canada)
$2.95
4-8 BUSINESS DAYS
PRIORITY SHIPPING
$14.95
3–5 BUSINESS DAYS
All P.O. boxes and remote locations
$8.95
6-8 BUSINESS DAYS
Please Note
- Orders are usually packed and ready to ship 1-2 business days after the order is placed
- A “business day” is considered to be Monday through Friday, excluding holidays
- Please allow 24-48 hours for tracking information to update once you receive a tracking number, some carriers have a delay in their system.
- International shipments are subject to customs clearance procedures, which can cause delays beyond the original delivery estimates
- Shipping, duties, taxes, and applicable fees are non-refundable for undeliverable or refused shipments nor for international shipments.
- International orders totals cannot exceed $300